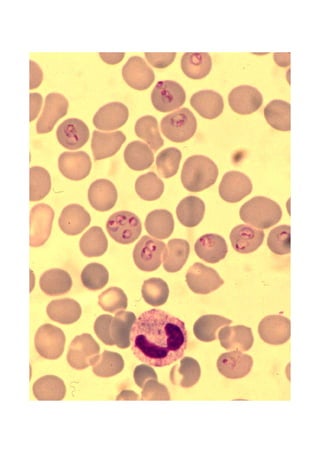

Le document traite des avancées dans le traitement du paludisme, en se concentrant sur de nouvelles stratégies de bithérapie pour contrer la résistance aux médicaments antipaludiques. Il présente des statistiques mondiales alarmantes sur l'incidence du paludisme et les résultats d'études cliniques sur différents traitements. Des combinaisons de médicaments, telles que l'artéméther-luméfantrine et la dihydroartémisinine-pipéraquine, sont mises en avant pour leur efficacité contre les souches résistantes.

![Stratégies de traitement-contrôle ou
traitement préventif ?
• Traitements curatifs des cas:
-Traitements présomptifs des fièvres
(pas de test biologique, enfants 0-5ans)
-ou diagnostics rapides (bandelettes ?) et traitements
précoces des vrais accès palustres
• Traitements intermittents systématiques:
-des enfants,à l’occasion des séances de
vaccination du PEV (2, 3 et 9 mois) ? ou plus souvent ?
-des femmes enceintes: 2 ou 3 cures lors des visites de
surveillance de la grossesse ++
→Prévention de la morbidité-mortalité (accès
graves, anémies [36% d’accès palustres en moins, enfants 10 mois-2
ans; voir: Schellenberg D et al. Lancet 2005;365:1481-3] ,….)](https://image.slidesharecdn.com/fac2006cdanis-130502102621-phpapp02/85/Medicaments-antipaludiques-nouvelles-bitherapies-strategies-de-changement-de-traitement-55-320.jpg)








